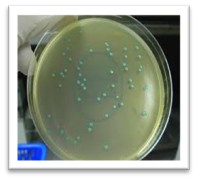
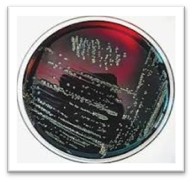
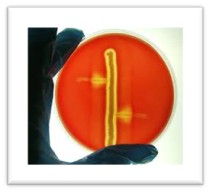

🔎👨🔬 اهمیت تشخیص Listeria Monocytogenes در مواد غذایی
1.مقدمه ای بر بیماری زایی لیستریا مونوسایتوژنز:
لیستریا مونوسایتوژنز، یک باکتری فرصت طلب گرم مثبت و پاتوژن درون سلولی است که به دلیل عفونت های انسانی ناشی از مواد غذایی ( مانند گوشت، مرغ و لبنیات) در سراسر جهان از اهمیت زیادی برخوردار می باشد. این باکتری یکی از مهم ترین عوامل بیماری زایی غذایی است که می تواند منجر به بیماری لیستریوزیس در انسان و حیوان شود. تظاهرات لیستریوزیس، شامل مننگوانسفالیت، سپتی سمی و سقط جنین به ویژه برای گروه های حساس مانند زنان باردار، نوزادان، سالمندان و افراد دارای ضعف سیستم ایمنی می باشد (1، 2)
جایگاه اولیه لیستریا مونوسایتوژنز، غالبا محیط می باشد و این باکتری در خاک، گیاهان در حالت فساد، آب و فاضلاب وجود دارد. از آنجایی که این باکتری یک باکتری فرصت طلب است و معمولا از طریق غذاهای از قبل آماده شده و فراورده های لبنی و گوشتی به انسان منتقل می شود و از طرفی به دلیل مقاومت بالای این باکتری نسبت به شرایط محیطی سخت از جمله غلظت بالای کلرید سدیم و PH اسیدی و همچنین دمای 4 درجه سلسیوس ( معادل دمای یخچال)، این باکتری به عنوان یکی از باکتری های مهم منتقل شونده از مواد غذایی و همچنین یک نگرانی عمده در بهداشت عمومی و صنعت غذایی در نظر گرفته می شود و تشخیص سریع و دقیق این باکتری در مواد غذایی برای پیشگیری از شیوع بیماری و حفاظت از سلامت عمومی ضروری است (3، 4 و 5).
🦠مورفولوژی Monocytogenes Listeria :
لیستریا مونوسایتوژنز، یک باسیل کوتاه، گرم مثبت، کاتالاز مثبت، متحرک و بدن اسپور است.

😷 مکانیزم بیماری زایی Listeria Monocytogenes
باکتری لیستریا مونوسایتوژنز، پس از خوردن غذاهای آلوده مانند لبنیات آلوده، از طریق دستگاه گوارش، وارد بدن انسان می شود. این باکتری دارای پروتئین های ادهیزن (adhesion) می باشد، که موجب اتصال باکتری به سلول میزبان می شود. پس از اتصال، وارد سلول های اپیتلیال شده و داخل یک فاگولیزوزوم محصور می شود. سپس توسط آنزیمی که دارد، غشاء فاگولیزوزوم را لیز کرده و به داخل سیتوپلاسم اپی تلیال می رود و در آنجا، شروع به تکثیر می کند، تکثیر زیاد باکتری در سلول موجب ایجاد برامدگی هایی به نام فیلوپود در سلول شده و سلول های مجاور، ماکروفاژها و هپاتوسیت ها آن را هضم کرده و مجددا لیستریا آزاد شده و این سیکل ادامه پیدا می کند(6). از طرف دیگر، این باکتری، به دلیل توانایی در پلی مریزاسیون اکتین، قادر به حرکت درون سلولی و بین سلولی ومقاومت در برابر دفاع ایمنی هومورال و در نهایت تکثیر در سلول میزبان می باشد (7).
مطالعات مختلف، حضور ژن های بیماری زایی مانند actA،prf A ,plc B ,plc A ,hly ,mpl را در لیستریا مونوسایتوژنز به اثبات رسانده است (8).

🦠 شناسایی و تشخیص Listeria Monocytogenes در مواد غذایی
طبق استاندارد ملی ایران به شماره 8035، پس از انتقال 25 گرم از نمونه در 250 میلی لیتر از محیط کشت مایع انتخابی اولیه Half Fraser broth که دارای ساپلمنت های اختصاصی اولیه ( کلرید لیتیم، اکریفلاوین و اسیدنالیدیک سیک) می باشد، انکوباسیون در دمای 30 درجه سلسیوس به مدت 24 ساعت، انجام می گیرد. پس از آن، 1/0 میلی لیتر از محلول فوق به 10 میلی لیتر محیط کشت مایع انتخابی ثانویه Fraser broth اضافه شده و به مدت 24 تا 48 ساعت در دمای 37 درجه سلسیوس، گرمخانه گذاری می شود. پس ازآن، از محیط مایع فوق، بر روی دو محیط کشت جامد انتخابی لیستریا آگار اوتاویانی و آگوستی (ALOA)، آکسفورد آگار(Oxford) و یا پالکام (PALCAM) به صورت سطحی، کشت داده می شود. پس از آن، انجام تست های تاییدی برروی کلنی های سبز-آبی تا خاکستری-مشکی (شکل 1 و2) بر روی محیط های جامد انتخابی کشت داده شده، انجام می گیرد (9).

🧪 آزمون های تاییدی Listeria Monocytogenes
همه گونه های لیستریا، در رنگ آمیزی گرم، نمای میله ای کوچک گرم مثبت دارند که در آزمون کاتالاز، واکنش مثبت نشان می دهند. لیستریا مونوسایتوژنز، دارای حرکت چرخشی خاص با نمای چترگونه در دمای 25 درجه سلسیوس است (شکل3). این باکتری، دارای همولیز بتا و دارای واکنش کمپ مثبت با سویه بتاهمولیتیک استافیلوکوکوس اورئوس و رودوکوکوس اکویی می باشد (9) ( شکل 4).

- مینا محمدی - کارشناس ارشد میکروبیولوژی
- آبان 10, 1404
- منابع :
- Cabanes D, Dehoux P, Dussurget O, FrangeulL , Cossart P. Surface proteins and the pathogenic potential of Listeria monocytogenes. Trends in Microbiol. 2002; 10 (5):238-45
- Liu D. Identification subtyping and virulence determination of Listeria monocytogenes an important foodborn pathogen. J Med Microbiol. 2006; 55: 645-659
- Carpentier B, Cerf O. Persistence of Listeria monocytogenes in food industry equipment and premises . International Journal of Food Microbiology. 2011; 145:1-8
- Jung SY, Frank JF, Brackett RE, Jinru C. Polymerase chain reaction detection of Listeria monocytogenes on frankfurters using oligonucleotide primers targeting the genes encoding internalin AB. Journal of Food Protection. 2003; 66(2):237-41
- Liu D; Lawrence ML; Anisworth AJ, Austin FW. Toward an improved laboratory definition of Listeria monocytogenes virulence. International Journal of Food Microbiology. 2007; 18:101-115
- Ramaswamy V; Cresence VM; Rejitha JS; Lekshmi MU; Dharsana KS; Prasad SP; Vijila HM. Listeria – review of epidemiology and pathogenesis. Journal of Microbiol Immunol Infect. 2007; 40(1): 4-13. PMID 17332901
- Sanger JM, Sanger JW, Southwick FS. Directional actin polymerization associated with spotted fever group Rickettsia infection of Vero cells. Infect Immun.1993; 60: 3609-3619
- Sleator RD, Gahan CG, Mand Hill C. Postgenomic of osmotolerance in Listeria monocytogenes. Appl Environ Microbiol. 2003; 69: 1-9.9
- Iranian National Standard No. 8035 - Microbiology of the Food Chain - Horizontal method for the detection, identification and enumeration of Listeria monocytogenes and Listeria species, detection and identification method. Second revision 1401(In Persian)
